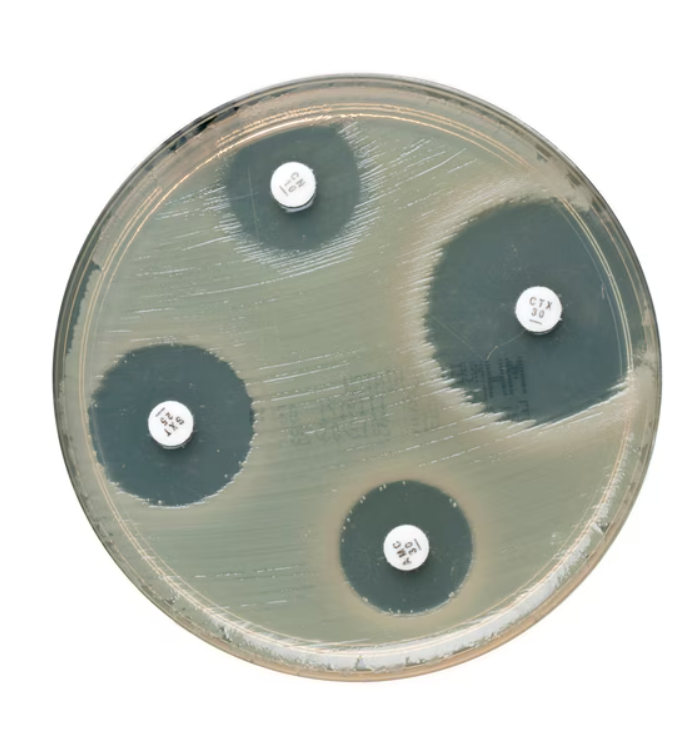
Mueller-Hinton Agar gotowa pożywka na płytkach Petriego 140 mm - 5szt

Podłoża mikrobiologiczne
Kategorie
Producent
Cena
-
od
do
 Mueller-Hinton Agar pożywka sypka 5kg
Mueller-Hinton Agar pożywka sypka 5kg
Podłoża sypkie
Producent:
OXOIDLTD
Cena:
3 221,51 zł
(netto:
2 982,88 zł
)
zawiera 8% VAT, bez kosztów dostawy
Mueller-Hinton Agar gotowa pożywka na płytkach Petriego 140 mm - 5szt
Mueller-Hinton Agar gotowa pożywka na płytkach Petriego 140 mm - 5szt
Podłoża gotowe na płytkach
Producent:
OXOIDLTD
Cena:
79,95 zł
(netto:
74,03 zł
)
zawiera 8% VAT, bez kosztów dostawy
 Mueller Hinton II Agar - gotowa pożywka na płytkach 140mm
Mueller Hinton II Agar - gotowa pożywka na płytkach 140mm
Podłoża gotowe na płytkach
Producent:
Liofilchem
Cena:
79,81 zł
(netto:
73,90 zł
)
zawiera 8% VAT, bez kosztów dostawy
 Mueller Hinton Agar with Sheep Blood gotowa pożywka na płytkach do oznaczania lekooporności
Mueller Hinton Agar with Sheep Blood gotowa pożywka na płytkach do oznaczania lekooporności
Podłoża gotowe na płytkach
Producent:
Oxoid
Cena:
25,62 zł
(netto:
23,72 zł
)
zawiera 8% VAT, bez kosztów dostawy
 Mueller Hinton Agar with Horse Blood + NAD gotowa pożywka na płytkach
Mueller Hinton Agar with Horse Blood + NAD gotowa pożywka na płytkach
Podłoża gotowe na płytkach
Producent:
Oxoid
Cena:
29,34 zł
(netto:
27,17 zł
)
zawiera 8% VAT, bez kosztów dostawy
 Mueller Hinton Agar pożywka sypka 500g
Mueller Hinton Agar pożywka sypka 500g
Podłoża sypkie
Producent:
OXOIDLTD
Cena:
256,05 zł
(netto:
237,08 zł
)
zawiera 8% VAT, bez kosztów dostawy
 Mueller Hinton Agar gotowa pożywka na płytkach do oznaczania lekowrażliwości
Mueller Hinton Agar gotowa pożywka na płytkach do oznaczania lekowrażliwości
Podłoża gotowe na płytkach
Producent:
Oxoid
Cena:
19,81 zł
(netto:
18,34 zł
)
zawiera 8% VAT, bez kosztów dostawy
 MUD/SF Medium plate (96 dołków) mikropłytka do zminiaturyzowanej metody NPL do oznaczania liczby enterokoków w wodach powierzchniowych i ściekach
MUD/SF Medium plate (96 dołków) mikropłytka do zminiaturyzowanej metody NPL do oznaczania liczby enterokoków w wodach powierzchniowych i ściekach
Podłoża gotowe na płytkach
Producent:
Biolab
Cena:
35,47 zł
(netto:
28,84 zł
)
zawiera 23% VAT, bez kosztów dostawy
 MSRV Selective Supplement - dodatek wybiórczy
MSRV Selective Supplement - dodatek wybiórczy
Dodatki wybiórcze
Producent:
Oxoid
Cena:
180,56 zł
(netto:
146,80 zł
)
zawiera 23% VAT, bez kosztów dostawy
 MSRV Medium Base pożywka sypka 500g do wykrywania gatunków Salmonella
MSRV Medium Base pożywka sypka 500g do wykrywania gatunków Salmonella
Podłoża sypkie
Producent:
OXOIDLTD
Cena:
256,43 zł
(netto:
208,48 zł
)
zawiera 23% VAT, bez kosztów dostawy
 MSRV Agar gotowa pożywka na płytkach Petriego LIOFILCHEM
MSRV Agar gotowa pożywka na płytkach Petriego LIOFILCHEM
Podłoża gotowe na płytkach
Producent:
Liofilchem
Cena:
77,99 zł
(netto:
63,41 zł
)
zawiera 23.00% VAT, bez kosztów dostawy
 MSRV Agar (ISO) pożywka sypka 500g do selektywnego wzbogacania Salmonella spp.
MSRV Agar (ISO) pożywka sypka 500g do selektywnego wzbogacania Salmonella spp.
Podłoża sypkie
Producent:
OXOIDLTD
Cena:
324,02 zł
(netto:
263,43 zł
)
zawiera 23% VAT, bez kosztów dostawy
darmowa i wygodna wysyłka
już od 800 zł netto
Najwyższa jakość
produktów potwierdzona certyfikatami
Zakupy 24h na dobę
wygodne i bezpieczne
bezpłatna konsultacja
z ekspertem online


